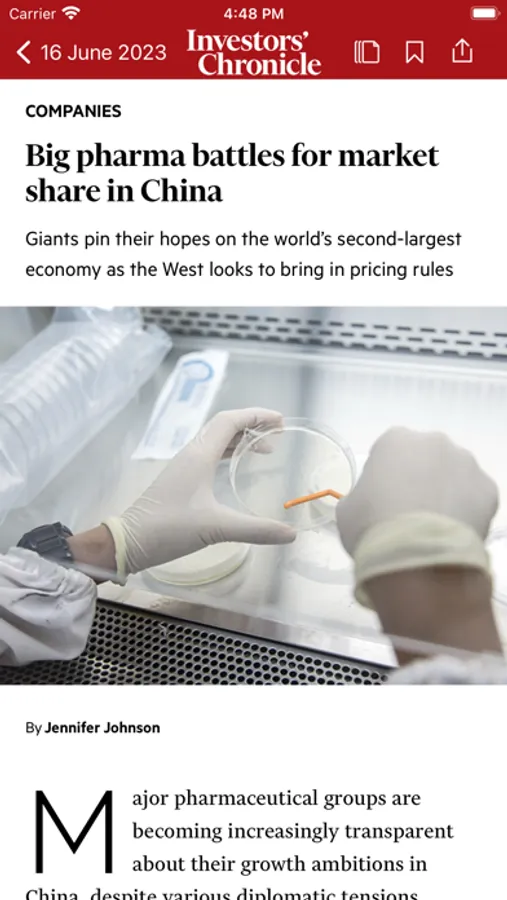

AppRecs review analysis
AppRecs rating 4.6. Trustworthiness 65 out of 100. Review manipulation risk 22 out of 100. Based on a review sample analyzed.
★★★★☆
4.6
AppRecs Rating
Ratings breakdown
5 star
71%
4 star
20%
3 star
4%
2 star
2%
1 star
2%
What to know
✓
Low review manipulation risk
22% review manipulation risk
✓
High user satisfaction
71% of sampled ratings are 5 stars
About Investors Chronicle
Subscribers with digital access can download all current and past issues. All other readers can purchase single issues within the app.
Features
• Each new issue will be available for you to download first thing every Friday.
• Once you have downloaded the issue to your device, you can read it wherever you are. An internet connection is no longer needed.
Designed for both mobile and tablet
• You’ll be able to read Investors Chronicle on your iPhone and your iPad.
• Our clearer to read font and distinct format is designed to make the magazine easier for you to read.
Search and discover
• Navigate your way around your favourite articles.
• Our new scrapbook feature allows you to conveniently store all your favourite articles and bookmarks in one place.
Complete read
• View all our content as featured in the weekly magazine, plus enjoy our suggested content from investorschronicle.co.uk.
About Investors Chronicle
Whether you’re a seasoned investor or just getting started, Investors Chronicle is the authoritative and independent source of market-beating fund and share tips, analysis and comprehensive coverage of the UK stock market. It has been helping investors make their money work harder for over 155 years.
An issue of Investors Chronicle will provide you with:
• Tips of the week. Uncover exciting share, bond and fund tips every week.
• Comprehensive companies coverage. We analyse over 1,000 company results each year to help you conduct thorough research when making investment decisions.
• Weekly features on big investment themes such as emerging markets and commodities.
• Funds coverage. Interviews with leading fund managers plus our in-depth research to help you find the best funds for growth and income.
• Online tip updates. Throughout the week we publish updates on our past stock picks.
• Isa and Sipp ideas. Ideas to take advantage of tax-efficient saving vehicles, including Isas and Sipps.
• Economic analysis. We'll give you the bigger picture, and help you understand the factors that affect your savings and investments.
• Trading ideas. 'The Trader' uses clearly explained charts to demonstrate how technical analysis helps them to anticipate market moves and informs his strategy.
Details on Apple Auto-renew subscription
• Title of publication or service: Investors Chronicle
• Length of subscription (time period and/or number of deliveries during each subscription period): 7 days subscription
• Price of subscription, and price per issue: £4.99
• Payment will be charged to iTunes Account at confirmation of purchase
• Subscription automatically renews unless auto-renew is turned off at least 24-hours before the end of the current period
• Account will be charged for renewal within 24-hours prior to the end of the current period, and identify the cost of the renewal
• Subscriptions may be managed by the user and auto-renewal may be turned off by going to the user's Account Settings after purchase
• No cancellation of the current subscription is allowed during active subscription period
• Any unused portion of a free trial period, if offered, will be forfeited when the user purchases a subscription to that publication.
LINKS:
Privacy Policy: http://www.ft.com/servicestools/help/privacy
Terms & Conditions: http://terms.ftspecialist.com
Investors Chronicle Screenshots
Tap to Rate:
Reviews for Investors Chronicle
Joesao
Progress, but...
This is certainly progress: having the entire issue on the iPad is great. Yet despite the retina display, the text is tiny and there is no way to make it larger, since this seems to be a replica of the print edition (and the iPad is much too small). It would be great if you could offer a proper digital edition Iike the Wall Street Journal or Barron's app, with adjustable font and other features.